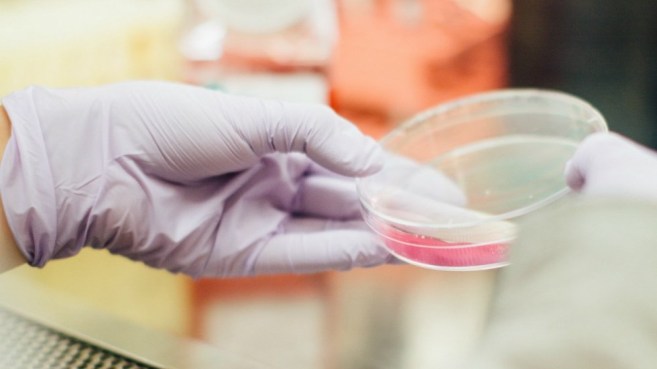

Los varones con antecedentes familiares de cáncer de mama tienen el doble riesgo de padecer cáncer de próstata, señaló este lunes un experto.
José Arturo Rodríguez Rivera, jefe del servicio de Urología del Hospital General de Occidente de Guadalajara, explicó que el factor genético de cáncer de mama en la familia también se debe considerar a la hora de analizar las posibilidades de tener cáncer de próstata.
Esto, dijo, se debe a que tanto el cáncer de mama como el de próstata son cánceres de tipo endocrinológico y relacionados con hormonas.
Rodríguez Rivera detalló que además del factor genético, biológico y de edad, hay otras causas relacionadas con hábitos que también predisponen a la aparición de la enfermedad.
Entre ellas se encuentra “pasar mucho tiempo sentado, tomar poca agua, aguantarse las ganas de orinar, tener el colesterol y triglicéridos altos, padecer sobrepeso y obesidad también van a predisponer al varón al cáncer de próstata”, agregó el especialista.
Añadió que diversos estudios han demostrado que la poca actividad sexual también eleva el riesgo de cáncer de próstata.
Rodríguez Rivera recomendó, con base en la fisiología de la próstata, que esta “debe de vaciarse un día sí y dos no”.
En tanto, Abraham Campos Romero, gerente del área de Investigación e Innovación de Salud Digna, indicó que el cáncer de próstata en México es más mortal que el cáncer de mama.
“En 2018 se registró la cifra de 7 mil hombres que fallecieron por cáncer de próstata contra 6.800 mujeres que mueren por cáncer de mama. Estamos hablando de que hoy van a morir 17 hombres por esta enfermedad”, subrayó.
Esto, enfatizó, se debe que este cáncer se detecta en etapas muy avanzadas porque es completamente asintomático.
En México cada vez va en aumento el número de casos entre hombres jóvenes.
Aunque en el 80 por ciento de los casos se da en hombres entre los 50 y 70 años.
Mientras que a nivel mundial, este cáncer se presenta a partir de los 60 años.
Los cinco estados que tienen registro más altos de cáncer de próstata son Coahuila, Chiapas, Sonora, Veracruz y Aguascalientes.
Para prevenir esta enfermedad los especialistas coincidieron en la realización de la prueba sanguínea de antígeno prostático a partir de los 40 años, aunada del tacto rectal y al ultrasonido.
Además del cambio de hábitos como “tomar un vaso de agua cada dos horas, nunca aguantarse las ganas de orinar, evitar el sobrepeso y obesidad y hacer ejercicio”, señaló Rodríguez Rivera.
De acuerdo con cifras de GLOBOCAN, una base estadística de cáncer de la Organización Mundial de la Salud (OMS), durante 2018 se diagnosticaron 1,3 millones de casos nuevos y se registraron 360 mil muertes alrededor del mundo.
En Latinoamérica surgieron cerca de 152.000 nuevos casos de cáncer y murieron 51 mil personas por esta causa.
En México, según datos del Instituto Mexicano del Seguro Social (IMSS), uno de cada siete hombres padecerá esta enfermedad en el transcurso de su vida.
Con información de EFE